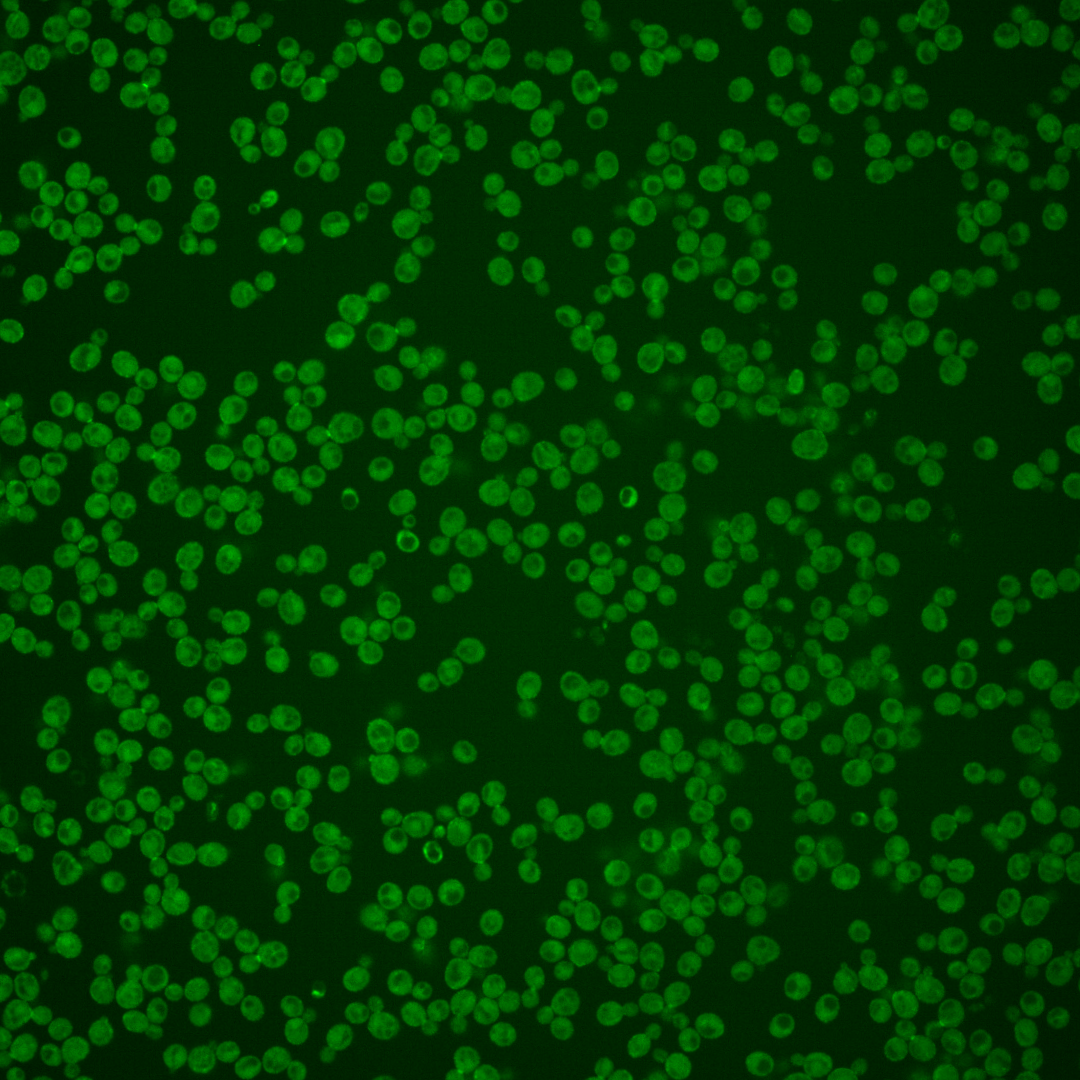
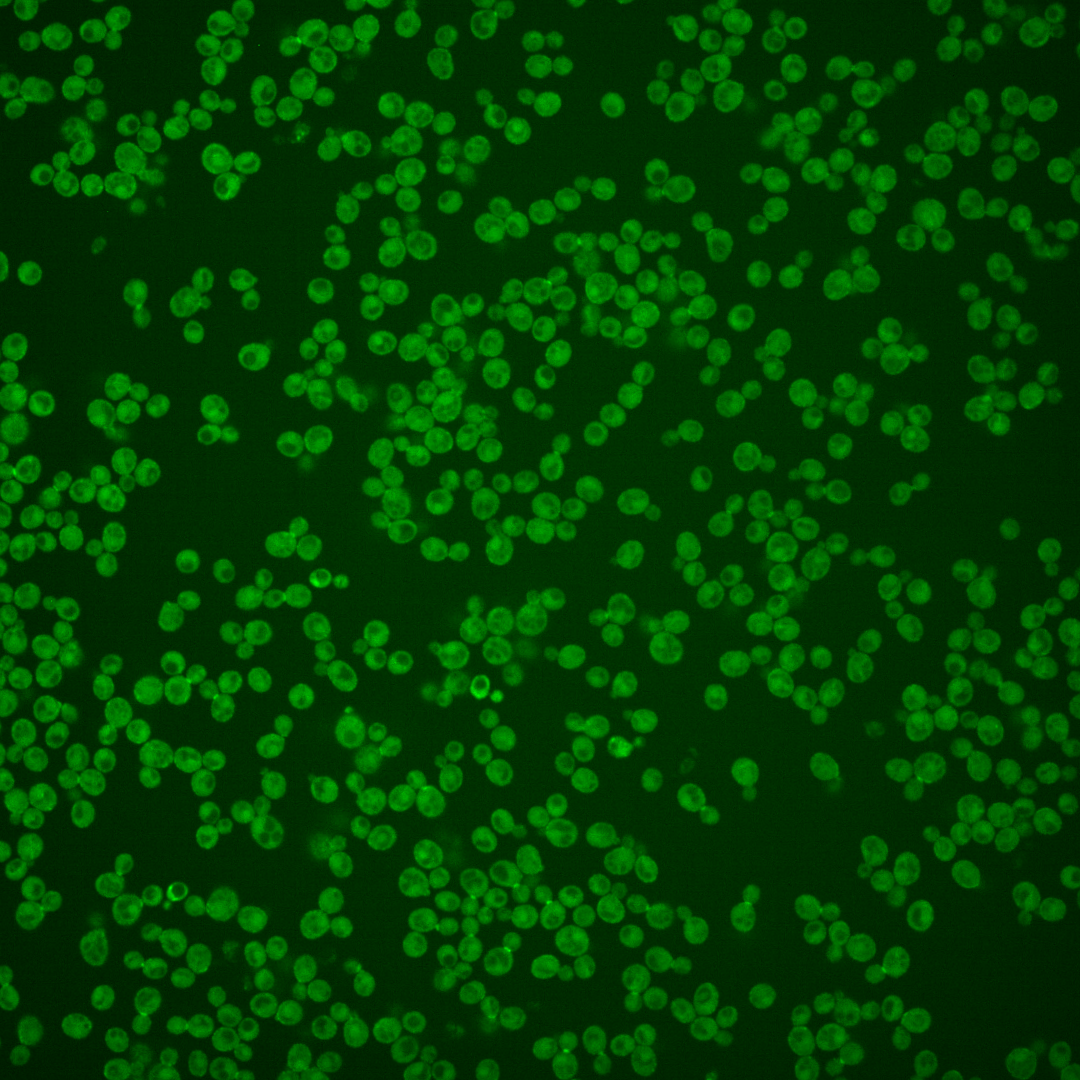
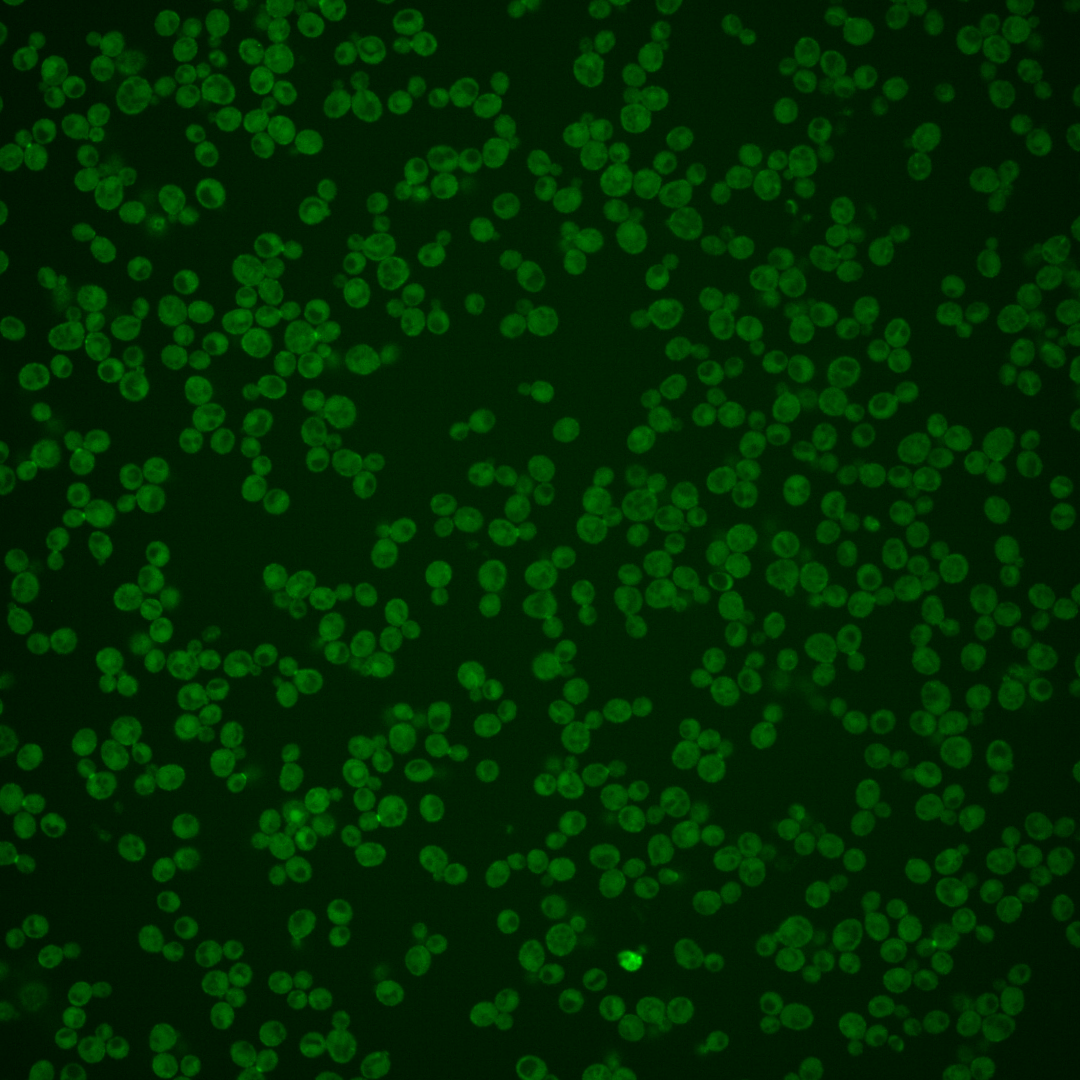
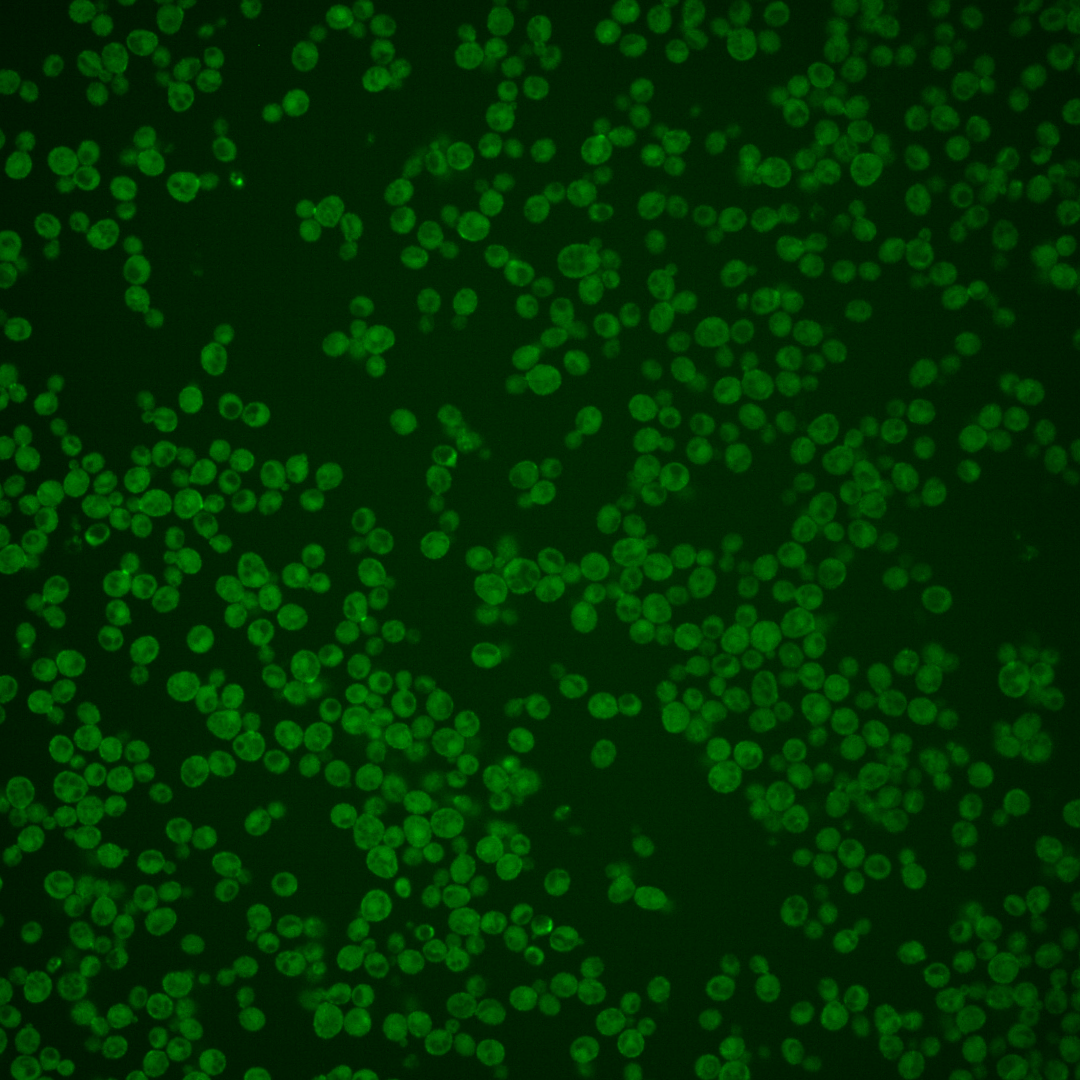

| Standard name | |
|---|---|
| Human Ortholog | |
| Description | Serine/threonine protein kinase; inhibits the mitotic exit network (MEN) when the spindle position checkpoint is activated; localized asymmetrically to mother cell cortex, spindle pole body and bud neck; KIN4 has a paralog, FRK1, that arose from the whole genome duplication |
Micrographs




















































































Sub-cellular Localization
Yeast GFP Assignment
Protein Abundance
Localization Change
External localization resources
| ensLOC | DeepLoc | |||||||||||||||||||||||
|---|---|---|---|---|---|---|---|---|---|---|---|---|---|---|---|---|---|---|---|---|---|---|---|---|
| Localization | WT1 | WT2 | WT3 | RAP60 | RAP140 | RAP220 | RAP300 | RAP380 | RAP460 | RAP540 | RAP620 | RAP700 | HU80 | HU120 | HU160 | rpd3Δ_1 | rpd3Δ_2 | rpd3Δ_3 | WT1 | WT2 | WT3 | AF100 | AF140 | AF180 |
| Cortical Patches | 28 | 18 | 30 | 16 | 45 | 33 | 26 | – | 20 | 10 | 13 | 11 | 31 | 9 | 7 | 42 | 30 | 19 | 15 | 24 | 20 | 25 | 33 | 26 |
| Bud | 14 | 41 | 11 | 10 | 13 | 11 | 14 | – | 21 | 22 | 28 | 16 | 27 | 12 | 8 | 10 | 3 | 3 | 2 | 13 | 6 | 7 | 2 | 9 |
| Bud Neck | 0 | 1 | 7 | 0 | 6 | 4 | 0 | – | 2 | 2 | 3 | 1 | 0 | 0 | 0 | 0 | 1 | 0 | 23 | 39 | 36 | 38 | 31 | 44 |
| Bud Site | 4 | 3 | 4 | 3 | 4 | 4 | 5 | – | 2 | 2 | 0 | 1 | 6 | 0 | 1 | 3 | 3 | 3 | – | – | – | – | – | – |
| Cell Periphery | 63 | 51 | 112 | 108 | 74 | 75 | 66 | – | 52 | 36 | 67 | 58 | 102 | 124 | 132 | 112 | 76 | 79 | 101 | 65 | 190 | 177 | 259 | 315 |
| Cytoplasm | 77 | 255 | 194 | 172 | 231 | 215 | 351 | – | 248 | 271 | 276 | 282 | 230 | 357 | 406 | 169 | 97 | 88 | 14 | 158 | 46 | 45 | 56 | 74 |
| Endoplasmic Reticulum | 3 | 2 | 0 | 0 | 4 | 9 | 5 | – | 4 | 1 | 4 | 1 | 0 | 0 | 1 | 17 | 8 | 5 | 14 | 24 | 10 | 10 | 17 | 18 |
| Endosome | 0 | 1 | 0 | 0 | 0 | 2 | 0 | – | 0 | 0 | 0 | 1 | 2 | 0 | 1 | 1 | 0 | 2 | 1 | 6 | 1 | 3 | 1 | 2 |
| Golgi | 0 | 0 | 0 | 0 | 0 | 0 | 0 | – | 0 | 0 | 0 | 0 | 0 | 0 | 0 | 2 | 3 | 1 | 0 | 0 | 0 | 2 | 0 | 1 |
| Mitochondria | 1 | 18 | 1 | 5 | 4 | 31 | 74 | – | 106 | 93 | 156 | 109 | 1 | 3 | 5 | 8 | 9 | 11 | 1 | 39 | 21 | 19 | 17 | 12 |
| Nucleus | 0 | 2 | 2 | 1 | 1 | 0 | 5 | – | 1 | 3 | 5 | 1 | 0 | 0 | 1 | 5 | 2 | 3 | 0 | 0 | 1 | 0 | 0 | 0 |
| Nuclear Periphery | 1 | 0 | 0 | 0 | 0 | 0 | 0 | – | 1 | 0 | 0 | 0 | 0 | 0 | 1 | 0 | 0 | 0 | 0 | 0 | 0 | 0 | 2 | 0 |
| Nucleolus | 0 | 0 | 0 | 0 | 0 | 0 | 0 | – | 0 | 0 | 0 | 0 | 0 | 0 | 0 | 0 | 0 | 0 | 0 | 1 | 0 | 0 | 0 | 0 |
| Peroxisomes | 2 | 0 | 0 | 0 | 0 | 0 | 1 | – | 1 | 0 | 0 | 0 | 1 | 4 | 2 | 0 | 3 | 0 | 0 | 0 | 0 | 0 | 1 | 0 |
| SpindlePole | 7 | 1 | 16 | 3 | 22 | 11 | 8 | – | 4 | 4 | 4 | 6 | 8 | 2 | 1 | 23 | 15 | 5 | 0 | 0 | 0 | 0 | 0 | 0 |
| Vac/Vac Membrane | 0 | 0 | 1 | 0 | 2 | 0 | 1 | – | 0 | 4 | 2 | 1 | 1 | 0 | 0 | 1 | 8 | 2 | 3 | 26 | 7 | 10 | 8 | 5 |
| Unique Cell Count | 150 | 333 | 280 | 234 | 320 | 317 | 460 | 359 | 366 | 429 | 381 | 303 | 394 | 443 | 312 | 198 | 183 | 182 | 408 | 347 | 349 | 439 | 518 | |
| Labelled Cell Count | 200 | 393 | 378 | 318 | 406 | 395 | 556 | 462 | 448 | 558 | 488 | 409 | 511 | 566 | 393 | 258 | 221 | 182 | 408 | 347 | 349 | 439 | 518 | |
Yeast GFP Assignment
Protein Abundance
| Screen | WT1 | WT2 | WT3 | RAP60 | RAP140 | RAP220 | RAP300 | RAP380 | RAP460 | RAP540 | RAP620 | RAP700 | HU80 | HU120 | HU160 | rpd3Δ_1 | rpd3Δ_2 | rpd3Δ_3 | AF100 | AF140 | AF180 |
|---|---|---|---|---|---|---|---|---|---|---|---|---|---|---|---|---|---|---|---|---|---|
| Mean Cell GFP Intensity (1e-4) | 5.9 | 4.7 | 6.2 | 5.8 | 6.1 | 5.2 | 5.3 | – | 4.5 | 4.4 | 4.3 | 4.8 | 5.6 | 5.4 | 5.6 | 8.0 | 8.7 | 8.0 | 5.4 | 5.5 | 5.8 |
| Std Deviation (1e-4) | 0.7 | 1.0 | 0.9 | 0.9 | 1.3 | 1.3 | 1.0 | – | 0.7 | 0.9 | 0.8 | 0.7 | 1.0 | 0.9 | 1.1 | 1.3 | 1.9 | 1.3 | 1.1 | 1.1 | 1.3 |
| Intensity Change (Log2) | – | – | – | -0.1 | -0.02 | -0.26 | -0.23 | – | -0.45 | -0.49 | -0.53 | -0.38 | -0.14 | -0.19 | -0.15 | 0.37 | 0.49 | 0.38 | -0.19 | -0.17 | -0.09 |
Localization Change
| Localization | RAP60 | RAP140 | RAP220 | RAP300 | RAP380 | RAP460 | RAP540 | RAP620 | RAP700 | HU80 | HU120 | HU160 | rpd3Δ_1 | rpd3Δ_2 | rpd3Δ_3 |
|---|---|---|---|---|---|---|---|---|---|---|---|---|---|---|---|
| Actin | – | – | – | – | – | – | – | – | – | – | – | – | – | – | – |
| Bud | – | – | – | – | – | – | – | – | – | – | – | – | – | – | – |
| Bud Neck | – | – | – | – | – | – | – | – | – | – | – | – | – | – | – |
| Bud Site | – | – | – | – | – | – | – | – | – | – | – | – | – | – | – |
| Cell Periphery | – | – | – | – | – | – | – | – | – | – | – | – | – | – | – |
| Cyto | – | – | – | – | – | – | – | – | – | – | – | – | – | – | – |
| Endoplasmic Reticulum | – | – | – | – | – | – | – | – | – | – | – | – | – | – | – |
| Endosome | – | – | – | – | – | – | – | – | – | – | – | – | – | – | – |
| Golgi | – | – | – | – | – | – | – | – | – | – | – | – | – | – | – |
| Mitochondria | – | – | – | – | – | – | – | – | – | – | – | – | – | – | – |
| Nuclear Periphery | – | – | – | – | – | – | – | – | – | – | – | – | – | – | – |
| Nuc | – | – | – | – | – | – | – | – | – | – | – | – | – | – | – |
| Nucleolus | – | – | – | – | – | – | – | – | – | – | – | – | – | – | – |
| Peroxisomes | – | – | – | – | – | – | – | – | – | – | – | – | – | – | – |
| SpindlePole | – | – | – | – | – | – | – | – | – | – | – | – | – | – | – |
| Vac | – | – | – | – | – | – | – | – | – | – | – | – | – | – | – |
| Cortical Patches | – | – | – | – | – | – | – | – | – | – | – | – | – | – | – |
| Cytoplasm | – | – | – | – | – | – | – | – | – | – | – | – | – | – | – |
| Nucleus | – | – | – | – | – | – | – | – | – | – | – | – | – | – | – |
| Vacuole | – | – | – | – | – | – | – | – | – | – | – | – | – | – | – |
External localization resources
Images






























Protein Concentration and Protein Localization Data
| R1 | R2 | R3 | ||||||||||||||||
|---|---|---|---|---|---|---|---|---|---|---|---|---|---|---|---|---|---|---|
| G1 Pre-START | G1 Post-START | S/G2 | Metaphase | Anaphase | Telophase | G1 Pre-START | G1 Post-START | S/G2 | Metaphase | Anaphase | Telophase | G1 Pre-START | G1 Post-START | S/G2 | Metaphase | Anaphase | Telophase | |
| Concentration | 2.8494 | 4.0846 | 3.5958 | 3.1449 | 3.393 | 3.7797 | 1.2847 | 2.109 | 2.0046 | 1.7719 | 1.4355 | 1.8331 | 0.653 | 2.0883 | 1.621 | 1.6484 | 1.4064 | 1.5961 |
| Actin | 0.0252 | 0.0033 | 0.0306 | 0.0009 | 0.0074 | 0.0106 | 0.0417 | 0.0048 | 0.026 | 0.006 | 0.0291 | 0.012 | 0.0433 | 0.0057 | 0.0026 | 0.0078 | 0.0101 | 0.0099 |
| Bud | 0.0007 | 0.0006 | 0.0013 | 0.0019 | 0.0023 | 0.0013 | 0.0026 | 0.0005 | 0.0023 | 0.0042 | 0.0021 | 0.0013 | 0.0013 | 0.0006 | 0.0008 | 0.0012 | 0.0013 | 0.0007 |
| Bud Neck | 0.0058 | 0.0083 | 0.0101 | 0.0099 | 0.1854 | 0.2434 | 0.0092 | 0.0059 | 0.0142 | 0.0096 | 0.0473 | 0.2387 | 0.0235 | 0.0045 | 0.0138 | 0.0218 | 0.0354 | 0.2883 |
| Bud Periphery | 0.0081 | 0.0032 | 0.0061 | 0.0238 | 0.0105 | 0.0088 | 0.0118 | 0.0016 | 0.0119 | 0.0202 | 0.0175 | 0.0116 | 0.0081 | 0.0017 | 0.0059 | 0.0144 | 0.0136 | 0.0063 |
| Bud Site | 0.0408 | 0.1424 | 0.0771 | 0.0128 | 0.0367 | 0.0067 | 0.0481 | 0.2146 | 0.0678 | 0.0181 | 0.0373 | 0.0057 | 0.0627 | 0.1857 | 0.0601 | 0.0251 | 0.0143 | 0.0033 |
| Cell Periphery | 0.2187 | 0.2166 | 0.3154 | 0.5856 | 0.1981 | 0.1779 | 0.2256 | 0.2695 | 0.3772 | 0.3696 | 0.5382 | 0.2578 | 0.2005 | 0.2108 | 0.3936 | 0.5416 | 0.4971 | 0.1944 |
| Cytoplasm | 0.3899 | 0.5168 | 0.4317 | 0.3538 | 0.3775 | 0.4813 | 0.427 | 0.4418 | 0.4035 | 0.3678 | 0.2131 | 0.3894 | 0.4436 | 0.5419 | 0.4516 | 0.3818 | 0.3196 | 0.4635 |
| Cytoplasmic Foci | 0.0107 | 0.0018 | 0.006 | 0.0004 | 0.013 | 0.0023 | 0.0252 | 0.0031 | 0.0114 | 0.0404 | 0.0097 | 0.0041 | 0.0187 | 0.0016 | 0.0034 | 0.0005 | 0.0073 | 0.0018 |
| Eisosomes | 0.0039 | 0.0018 | 0.0025 | 0.001 | 0.0028 | 0.0006 | 0.003 | 0.0018 | 0.0026 | 0.0006 | 0.0014 | 0.0008 | 0.0041 | 0.001 | 0.0012 | 0.0007 | 0.0019 | 0.0003 |
| Endoplasmic Reticulum | 0.0054 | 0.0029 | 0.0043 | 0.0024 | 0.0049 | 0.003 | 0.0103 | 0.0039 | 0.0057 | 0.0043 | 0.0072 | 0.0018 | 0.0083 | 0.0019 | 0.0026 | 0.0014 | 0.0021 | 0.0016 |
| Endosome | 0.0053 | 0.0003 | 0.0055 | 0 | 0.0013 | 0.0055 | 0.0303 | 0.0011 | 0.0085 | 0.0402 | 0.0198 | 0.0056 | 0.0105 | 0.0002 | 0.0012 | 0 | 0.0135 | 0.0017 |
| Golgi | 0.0019 | 0.0005 | 0.0037 | 0.0002 | 0.0012 | 0.0029 | 0.0177 | 0.0004 | 0.0059 | 0.0134 | 0.0207 | 0.0038 | 0.005 | 0.0003 | 0.0018 | 0.0002 | 0.0058 | 0.0008 |
| Lipid Particles | 0.0084 | 0.0015 | 0.0075 | 0.0003 | 0.0032 | 0.0045 | 0.0198 | 0.0013 | 0.0091 | 0.0255 | 0.0072 | 0.0045 | 0.0097 | 0.0005 | 0.004 | 0.0002 | 0.0079 | 0.0004 |
| Mitochondria | 0.0011 | 0.0001 | 0.0044 | 0.0001 | 0.0027 | 0.0028 | 0.0143 | 0.0001 | 0.0041 | 0.006 | 0.0254 | 0.0082 | 0.0125 | 0.0001 | 0.008 | 0 | 0.0103 | 0.0001 |
| None | 0.2457 | 0.0964 | 0.076 | 0.0037 | 0.143 | 0.0396 | 0.0704 | 0.0474 | 0.0338 | 0.032 | 0.0132 | 0.0442 | 0.1213 | 0.0414 | 0.0345 | 0.0011 | 0.0193 | 0.0227 |
| Nuclear Periphery | 0.0033 | 0.0002 | 0.0031 | 0.0001 | 0.0002 | 0.0015 | 0.0088 | 0.0002 | 0.0015 | 0.0022 | 0.0019 | 0.0006 | 0.0024 | 0.0001 | 0.0002 | 0.0001 | 0.011 | 0.0015 |
| Nucleolus | 0.0015 | 0.0002 | 0.0006 | 0.0001 | 0.002 | 0.0004 | 0.001 | 0.0001 | 0.0005 | 0.0013 | 0.0003 | 0.0006 | 0.0017 | 0.0001 | 0.0002 | 0.0001 | 0.0006 | 0.0001 |
| Nucleus | 0.0039 | 0.0004 | 0.001 | 0.0003 | 0.0009 | 0.0007 | 0.0094 | 0.0004 | 0.0015 | 0.0034 | 0.0011 | 0.001 | 0.0012 | 0.0003 | 0.0004 | 0.0002 | 0.0016 | 0.0005 |
| Peroxisomes | 0.0062 | 0.0001 | 0.0077 | 0 | 0.0016 | 0.0021 | 0.0124 | 0.0003 | 0.0079 | 0.0137 | 0.0025 | 0.0024 | 0.014 | 0.0001 | 0.0117 | 0 | 0.0104 | 0.0003 |
| Punctate Nuclear | 0.0091 | 0.0002 | 0.0017 | 0 | 0.0004 | 0.001 | 0.003 | 0.0002 | 0.001 | 0.0046 | 0.001 | 0.0034 | 0.0017 | 0.0001 | 0.0002 | 0 | 0.0146 | 0.0005 |
| Vacuole | 0.004 | 0.0023 | 0.0033 | 0.0025 | 0.0048 | 0.0026 | 0.0067 | 0.001 | 0.0032 | 0.0149 | 0.0035 | 0.002 | 0.0052 | 0.0014 | 0.0024 | 0.0016 | 0.0016 | 0.0012 |
| Vacuole Periphery | 0.0004 | 0 | 0.0003 | 0 | 0.0003 | 0.0003 | 0.0017 | 0 | 0.0003 | 0.002 | 0.0006 | 0.0004 | 0.0006 | 0 | 0.0001 | 0 | 0.0007 | 0.0001 |
Sequencing Data
| R1 | R2 | |||||||||
|---|---|---|---|---|---|---|---|---|---|---|
| G1 Post-START | S/G2 | Metaphase | Anaphase | Telophase | G1 Post-START | S/G2 | Metaphase | Anaphase | Telophase | |
| Gene Expression | 22.7293 | 21.7553 | 11.2699 | 14.913 | 19.6464 | 16.0623 | 21.7892 | 19.7484 | 14.7682 | 24.7295 |
| Translational Efficiency | 0.6353 | 0.7058 | 0.813 | 0.5596 | 0.5595 | 0.76 | 0.7935 | 0.5105 | 0.5851 | 0.5156 |
Hit Data
| Dataset | Hit |
|---|---|
| Protein Concentration | ✔ |
| Protein Localization | ✔ |
| Gene Expression | ✘ |
| Translational Efficiency | ✘ |
Endocytosis
| Temp | Actin Patch (Sac6-tdTomato) | Cortical Patch (Sla1-GFP) | Late Endosome (Snf7-GFP) | Vacuole (Vph1-GFP) |
|---|---|---|---|---|
| 37℃ | ||||
| RT |
Cell Cycle Omics
CYCLoPs (Kin4-GFP)
| Gene / Allele | Actin Patch (Sac6-tdTomato) | Cortical Patch (Sla1-GFP) | Late Endosome (Snf7-GFP) | Vacuole (Sac6-tdTomato) |
|---|
| Gene | Images |
|---|
| Gene | Images |
|---|
Images are not yet available
Images are not yet available